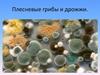
Плесневые грибы и дрожжи

Similar presentations:
Плесневые грибы и дрожжи. 5 класс. Конкурс педагогических разработок
1.
Конкурс педагогических разработокучителей естественно-математического
цикла «Современный урок:
формирование понятий»
Урок биологи в 5 классе
«ПЛЕСНЕВЫЕ ГРИБЫ И ДРОЖЖИ»
Автор: Конина Н.А.,
учитель биологии МБОУ СОШ № 6
2.
ПРОВЕРКА ДОМАШНЕГО ЗАДАНИЯ1.Как называется наука, изучающая строение и
функции грибов?
2.На какие группы делятся грибы?
3.Приведите примеры съедобных и ядовитых
шляпочных грибов.
4.В чем отличие спор грибов от спор бактерий?
3. Вопрос
Какие из названных грибов относятся ктрубчатым, а какие к пластинчатым:
1.
2.
3.
4.
5.
6.
7.
8.
9.
10.
маслята
рыжики
белые грибы
подберёзовики
лисички
подосиновики
сыроежки
шампиньоны
опята
грузди
3
4. Трубчатые
45. Пластинчатые
56. Вопрос
Почему лоси и другие копытныеживотные поедают мухоморы?
6
7. Вопрос
Какиегрибы
ищут
выдрессированными
со
специально
собаками,
а
во
Франции – с домашними свиньями?
7
8. Отгадайте загадки
Я старушка вредная,На мне шляпка бледная,
А нога в ботинке,
На чулке пестринки,
Кто меня коснётся,
Тот уже не проснётся.
Мы весёлые ребята
А зовут все нас… .
Так назвали нас не зря:
Мы на пне живём,
друзья.
8
9.
Хлеба белого кусокждал тебя, да вышел срок.
Что мерцает под столом
помутнелым серебром?
Может, плесень?
Верно, плесень!
10.
Тесто быстро поднимают,Кто печёт – тот это знает,
Сохранить сухими можно.
Догадались? Это - ……
11. Тема урока «Плесневые грибы и дрожжи»
12. Цель урока
изучить особенности строения иусловия
жизни
плесневых
грибов и дрожжей, выяснить их
роль
в
природе
и
жизни
человека.
13.
14.
15.
16.
17.
18.
19. Выполнение практической работы
1. Приготовьте микропрепарат гриба мукора поалгоритму из раздаточного материала.
2. Рассмотрите
строение
гриба
мукора.
Сравните с рисунком из учебника.
3. Сравните с готовым препаратом.
4. Зарисуйте и подпишите увиденное с рисунка
учебника и слайда.
20.
21. РАЗМНОЖЕНИЕ ДРОЖЖЕЙ
22. Выполнение практической работы
Приготовьтемикропрепарат
дрожжей
(по
Сравните с рисунком на слайде и
из
алгоритму).
учебника (стр.79).
Зарисуйте
клетку
дрожжей
названия ее основных частей.
и
подпишите
23. Продолжите предложение…
1)Пекарь для пышности теста добавит…2)Для
получения
лекарства
будут
выращивать…
3)Грибница
представляет
собой
разросшуюся многоядерную …, это….
одну
24. АНКЕТА
На уроке я работал…Активно/ пассивно
Своей работой на уроке я … Доволен /недоволен
Урок был..
Интересным/скучным
За урок я …
Не устал/устал
Настроение мое …
Улучшилось / стало хуже
Материал урока мне был…
Понятен/ не понятен
25. Домашнее задание
Параграф 151 группа – Выпишите вред и пользу плесневых
грибов
2 группа - Предложите меры защиты от плесени.
3 группа - Возможно, вы слышали про
"Проклятье Фараонов"? Какие организмы и за что
получили такое название?
Сочинить сказку про «Плесень» (по
желанию).


























 biology
biology